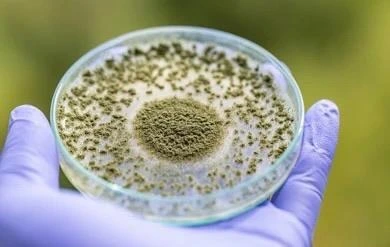

Home





Our Core Offerings
Our core offerings encompass a diverse range of scientifically validated reagents, laboratory consumables, specialty solvents, and advanced research kits tailored to support modern laboratory workflows. Each product is sourced and delivered with a commitment to quality, consistency, and technical excellence, enabling accurate results and enhanced operational efficiency across research and industrial environments.

BCA Estimation Kit with Protein Standard
Select options This product has multiple variants. The options may be chosen on the product page
Pro Green One-Step RT-PCR Kit
Select options This product has multiple variants. The options may be chosen on the product page
ProGel/PCR Cleanup Kit
Select options This product has multiple variants. The options may be chosen on the product page
ProDNA Extraction (Plant)
Select options This product has multiple variants. The options may be chosen on the product page
ProDNA Extraction (Whole Blood)
Select options This product has multiple variants. The options may be chosen on the product page
ProPlasmid Extraction (Bacterial)
Select options This product has multiple variants. The options may be chosen on the product page
Tri Base
Select options This product has multiple variants. The options may be chosen on the product page
HEPES-Na
Select options This product has multiple variants. The options may be chosen on the product page
Pro Agarose, Low EEO
Select options This product has multiple variants. The options may be chosen on the product page
HEPES
Select options This product has multiple variants. The options may be chosen on the product page
MOPS
Select options This product has multiple variants. The options may be chosen on the product page

2-Propanol
Select options This product has multiple variants. The options may be chosen on the product page
Phos-tag (TM) Acrylamide
Select options This product has multiple variants. The options may be chosen on the product page
RPMI-1640 with L-Glutamine and Phenol Red
Select options This product has multiple variants. The options may be chosen on the product page
Potassium Hydroxide
Select options This product has multiple variants. The options may be chosen on the product page
Citric Acid
Select options This product has multiple variants. The options may be chosen on the product page
2-Amino-2-Hydroxymethyl-1
Select options This product has multiple variants. The options may be chosen on the product page
Activator Solution 4
Select options This product has multiple variants. The options may be chosen on the product page

Aurora® Ultimate™ 25×75 C18 UHPLC column
Select options This product has multiple variants. The options may be chosen on the product page
Aurora® Rapid™ 8×75 XT C18 HeatSync™ Starter Pack
Select options This product has multiple variants. The options may be chosen on the product page
Aurora® Rapid™ 8×75 CSI C18 UHPLC column
Select options This product has multiple variants. The options may be chosen on the product page
Aurora® Rapid™ 8×150 XT C18 UHPLC column
Select options This product has multiple variants. The options may be chosen on the product page
Aurora® Rapid™ 8×150 XT C18 HeatSync™ Starter Pack
Select options This product has multiple variants. The options may be chosen on the product page
Aurora® Ultimate™ 25×150 C18 UHPLC column
Select options This product has multiple variants. The options may be chosen on the product page
Aurora® Frontier™ 60×75 XT C18 UHPLC column
Select options This product has multiple variants. The options may be chosen on the product page
Aurora® Rapid™ 5×75 CSI C18 UHPLC Column
Select options This product has multiple variants. The options may be chosen on the product page
Aurora® Frontier™ 60×75 CSI C18 UHPLC column
Select options This product has multiple variants. The options may be chosen on the product page

GM quicker
Select options This product has multiple variants. The options may be chosen on the product page
ISOGEN with Spin Column
Select options This product has multiple variants. The options may be chosen on the product page
ISOGEN, ISOGEN-LS
Select options This product has multiple variants. The options may be chosen on the product page
ISOSPIN Cell & Tissue RNA
Select options This product has multiple variants. The options may be chosen on the product page
ISOSPIN Viral RNA Kit
Select options This product has multiple variants. The options may be chosen on the product page
ISOSPIN Plant DNA
Select options This product has multiple variants. The options may be chosen on the product page
ISOSPIN Agarose Gel
Select options This product has multiple variants. The options may be chosen on the product page
ISOSPIN PCR Product
Select options This product has multiple variants. The options may be chosen on the product page
Water, Nuclease-free
Select options This product has multiple variants. The options may be chosen on the product pageApplications We Support
Learning
Resources
Company
Highlights

Literature
Explore our comprehensive portfolio of catalogs, brochures, and technical datasheets from our esteemed principals, meticulously compiled to present cutting-edge innovations, in-depth product specifications, and rigorously validated solutions.

Our Principal Supplier
We collaborate with globally recognized and trusted principal suppliers to deliver premium-quality laboratory consumables, analytical solvents, diagnostic kits, molecular biology reagents, and allied scientific solutions.
Proteogenixx has strategically showcased its innovations and product portfolio at premier scientific exhibitions and industry forums, fostering high level engagement with the global life-sciences research community.
Road Show - CCMB, Hyderabad
Road Show - HITEX 2025






Pioneering Work on Aflatoxin Detection & Mitigation
Within this vibrant ecosystem, our team is dedicated to addressing the formidable global challenge of aflatoxin contamination—a critical threat to food security, human health, and agricultural sustainability. Our initiatives encompass:
Proteogenixx Lifescience Pvt. Ltd. is accomplishing a structured research and development project at BBB–RCB, Faridabad, focused on advancing analytical tools and reference standards for aflatoxin monitoring in food and feed matrices. “This Project is being conducted with due approval from the Review Committee on Genetic Manipulation (RCGM), Government of India, ensuring compliance with applicable biosafety and regulatory guidelines.” includes the following Technical objectives: Read more…
Pioneering Work on Aflatoxin
Proteogenixx Lifescience Pvt. Ltd. is presently engaged in a structured and scientifically rigorous collaborative research program at BBB–RCB (Regional Centre for Biotechnology). This partnership is designed to integrate industrial research capabilities with advanced institutional infrastructure in order to develop strong, high-sensitivity analytical platforms of translational and regulatory significance.



Reliable Research
Transforming Ideas into Pioneering Advancements
Trusted by premier research institutes, universities, and scientific organizations nationwide









Professional Endorsement
Dr. Srikanth
Dr. Srikanth, Regional Centre for Biotechnology (RCB) has also endorsed our Protein Ladder, acknowledging its precise molecular weight calibration, consistent band sharpness, and reliable reproducibility across repeated electrophoretic runs. The product has been validated for routine laboratory use, demonstrating stability, analytical accuracy, and dependable performance outcomes.
Dr. Neeru Saini
Dr. Neeru Saini, Council of Scientific and Industrial Research – Institute of Genomics and Integrative Biology (CSIR–IGIB) has reported highly satisfactory performance of our Protein Ladder and RIPA Buffer, citing sharp band clarity, consistent signal intensity, and efficient cellular lysis with optimal protein recovery. The buffer system demonstrated effective solubilization while maintaining protein integrity for downstream immunodetection and molecular analyses.
Dr. Ramu S. Verma
Dr. Ramu S. Verma, Regional Centre for Biotechnology (RCB) has technically approved our BCA Protein Assay Kit, emphasizing its high sensitivity, extended linear dynamic range, and consistently strong R² values, reflecting robust standard curve correlation and analytical precision. The assay exhibited minimal inter-assay variability and dependable quantification accuracy, supporting reproducible protein estimation in advanced research applications.
Dr. Deepti Jain
Dr. Deepti Jain, Regional Centre for Biotechnology (RCB) has rigorously evaluated our Protein Ladder and affirmed its exceptional band resolution, uniform intensity distribution, and precise molecular weight demarcation across a broad size range. The ladder demonstrated excellent stability and reproducibility, facilitating accurate gel documentation and reliable comparative analysis in routine electrophoretic workflows.



















































